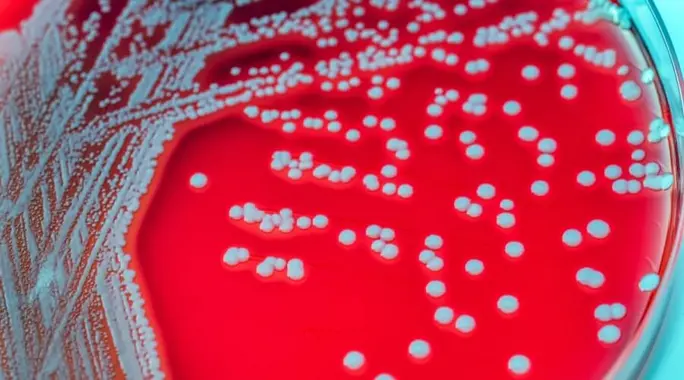

ملاحظة وجود دم في البول، المعروف طبياً باسم “البيلة الدموية”، قد يكون أمراً مقلقاً للكثيرين. يتراوح ظهور كريات الدم الحمراء في البول من حالة غير مرئية بالعين المجردة (مجهرية) إلى ظهور واضح يغير لون البول إلى الوردي أو الأحمر.
في حين أن البيلة الدموية يمكن أن تكون حميدة في بعض الأحيان، إلا أنها قد تشير أيضاً إلى مشكلة صحية كامنة تتطلب اهتماماً طبياً. سيساعدك هذا المقال على فهم الأسباب الشائعة لظهور كريات الدم الحمراء في البول، والعوامل التي تزيد من خطرها، وكيفية تشخيصها وعلاجها.
جدول المحتويات
- ما هي كريات الدم الحمراء في البول؟
- أسباب ظهور كريات الدم الحمراء في البول
- العوامل التي تزيد من خطر ظهور كريات الدم الحمراء في البول
- الأعراض المصاحبة لظهور كريات الدم الحمراء في البول
- تشخيص وجود كريات الدم الحمراء في البول
- علاج كريات الدم الحمراء في البول
- خاتمة
ما هي كريات الدم الحمراء في البول؟
تشير كريات الدم الحمراء في البول، أو ما يُعرف بالبيلة الدموية، إلى وجود خلايا الدم الحمراء في عينة البول. يمكن أن تكون هذه الحالة مرئية بالعين المجردة، حيث يظهر البول بلون وردي أو أحمر أو حتى بني داكن، أو قد تكون مجهرية لا تُرى إلا تحت المجهر.
لا يعني ظهور الدم في البول دائماً وجود مشكلة خطيرة، ولكنه يتطلب تقييماً طبياً لتحديد السبب الأساسي وضمان عدم وجود حالة كامنة تستدعي العلاج.
أسباب ظهور كريات الدم الحمراء في البول
تتعدد الأسباب الكامنة وراء ظهور كريات الدم الحمراء في البول، بدءاً من الحالات البسيطة إلى الأمراض الأكثر خطورة. إليك أبرز هذه الأسباب:
التهاب المسالك البولية
يُعد التهاب المسالك البولية أحد الأسباب الشائعة لوجود الدم في البول. يحدث هذا الالتهاب غالباً نتيجة لتكاثر البكتيريا في مجرى البول، خاصةً في المثانة أو الكلى.
قد تلاحظ مع هذا الالتهاب أعراضاً أخرى مثل الشعور بحرقة أثناء التبول، والحاجة المتكررة للتبول، ووجود رائحة كريهة للبول.
حصى الكلى
تتكون حصى الكلى نتيجة لتجمع الرواسب المعدنية في الكلى أو المثانة. تسبب هذه الحصوات ألماً شديداً عند انسدادها أو مرورها عبر المسالك البولية.
يمكن أن تؤدي حركة الحصوات إلى تهيج الأنسجة ونزفها، مما يسبب ظهور كريات الدم الحمراء في البول، سواء بشكل مرئي أو مجهري.
مشكلات البروستاتا
عند الرجال، يمكن أن تتسبب مشكلات البروستاتا، مثل تضخم البروستاتا الحميد أو التهابها، في ظهور الدم في البول. تضغط البروستاتا المتضخمة على الإحليل، مما يؤدي إلى تهيج ونزيف.
ترافق هذه الحالة غالباً أعراض أخرى مثل ألم أثناء التبول، وصعوبة في بدء التبول، والحاجة المتكررة للتبول ليلاً.
السرطان
في بعض الحالات، قد يكون ظهور كريات الدم الحمراء في البول مؤشراً على وجود أنواع معينة من السرطان، مثل سرطان الكلى أو سرطان المثانة أو سرطان البروستاتا. من المهم الإشارة إلى أن هذه الأنواع من السرطانات قد لا تظهر لها أعراض واضحة في مراحلها المبكرة.
أسباب أخرى
توجد أسباب أخرى متنوعة يمكن أن تؤدي إلى ظهور دم في البول، منها:
- إصابة الكلى، سواء كانت نتيجة لصدمة أو جرح مباشر.
- تناول بعض الأدوية، خاصةً مميعات الدم مثل الأسبرين.
- ممارسة التمارين الرياضية المكثفة والشاقة، والتي يمكن أن تسبب تلفاً مؤقتاً في الكلى أو المثانة.
- وجود تكيسات على الكلى (الكلى متعددة الكيسات).
- الجماع في بعض الأحيان، خاصةً إذا كان هناك تهيج سابق في المسالك البولية.
العوامل التي تزيد من خطر ظهور كريات الدم الحمراء في البول
تزيد بعض العوامل من احتمالية ظهور كريات الدم الحمراء في البول. انتبه لهذه العوامل لتقييم مدى خطورة حالتك:
- التقدم في السن: يزداد خطر الإصابة، خاصةً عند الرجال فوق الخمسين، بسبب زيادة فرصة مشكلات البروستاتا.
- الالتهابات: تُعزز العدوى البكتيرية أو الفيروسية من احتمالية حدوث بيلة دموية.
- التاريخ العائلي: يزيد وجود تاريخ عائلي لأمراض الكلى أو حصى الكلى من خطر إصابتك.
- ممارسة الرياضة المكثفة: يتعرض الرياضيون، وخصوصاً العدّاؤون، لخطر أكبر لظهور الدم في البول بعد المجهود البدني الشديد.
الأعراض المصاحبة لظهور كريات الدم الحمراء في البول
يمكن أن تترافق البيلة الدموية مع مجموعة من الأعراض التي تشير إلى السبب الكامن وراءها. راقب هذه العلامات:
- تغير لون البول إلى الوردي، الأحمر، أو حتى بلون الشاي الداكن.
- الشعور بالحاجة المتكررة والمفاجئة للتبول.
- ألم أو حرقة أثناء التبول (عسر التبول).
- وجع في منطقة الظهر أو البطن.
- انتفاخ في الأقدام أو الكواحل (تورم).
تشخيص وجود كريات الدم الحمراء في البول
عند ملاحظة أي من الأعراض المذكورة، من الضروري استشارة الطبيب لتحديد السبب الدقيق. سيبدأ الطبيب بمراجعة تاريخك الطبي وإجراء فحص جسدي، ثم قد يطلب بعض الفحوصات التشخيصية:
فحص البول
يعد فحص البول أداة أساسية للكشف عن كريات الدم الحمراء، وأيضاً لتحديد أسباب محتملة مثل التهاب المسالك البولية أو وجود ترسبات قد تشير إلى حصى الكلى. يكشف هذا الفحص عن وجود الدم، البكتيريا، والبروتين في البول.
التصوير الطبي
تساعد تقنيات التصوير المختلفة في الكشف عن المشكلات الهيكلية في الجهاز البولي. يمكن أن يشمل ذلك التصوير بالموجات فوق الصوتية، أو الأشعة المقطعية (CT)، أو التصوير بالرنين المغناطيسي (MRI) لتصوير الكلى والمثانة والحالبين.
تنظير المثانة
في هذا الإجراء، يُدخل الطبيب أنبوباً رفيعاً مزوداً بكاميرا (منظار المثانة) عبر الإحليل لفحص المثانة والإحليل من الداخل. يساعد هذا في الكشف عن أي شذوذات أو أورام أو مصادر للنزيف داخل المثانة.
علاج كريات الدم الحمراء في البول
يعتمد علاج كريات الدم الحمراء في البول بشكل كلي على تحديد السبب الأساسي. بمجرد تشخيص المشكلة، يضع الطبيب خطة علاج مناسبة:
- إذا كان السبب التهاب المسالك البولية، فإن المضادات الحيوية تُستخدم للتخلص من العدوى البكتيرية.
- في حالات تضخم البروستاتا، قد يصف الطبيب أدوية معينة لتقليص حجم البروستاتا أو لتخفيف الأعراض.
- بالنسبة لحصى الكلى، يمكن علاجها عن طريق شرب الكثير من السوائل لتسهيل مرور الحصى الصغيرة، أو قد تتطلب إجراءات طبية مثل تفتيت الحصى بالموجات الصادمة، أو الاستئصال الجراحي للحصوات الكبيرة.
خاتمة
إن وجود كريات الدم الحمراء في البول هو علامة يجب ألا تتجاهلها. على الرغم من أن العديد من الأسباب قد تكون بسيطة وغير خطيرة، إلا أن بعضها يتطلب تدخلاً طبياً عاجلاً لتجنب المضاعفات.
لذلك، إذا لاحظت أي تغير في لون بولك أو أي من الأعراض المصاحبة، فمن الضروري مراجعة الطبيب للحصول على التشخيص الدقيق والعلاج المناسب. صحتك تستحق الاهتمام!